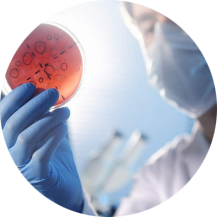

- Overall Immunoassay
- 整体免疫检测
-

整体免疫功能检测
-

整体免疫体液检测
-
整体免疫体细胞生化检测
-

整体免疫体细胞影像检测

检测的最终目的

- 正确指导头面部免疫排毒和审美设计,实现青春免疫,回归自然之美;

- 准确定位引起美丢失和一切健康问题的毒素根源;

- 准确评估细胞整体免疫和细胞信号源缺失情况;

- 正确指导整体免疫治疗,实现生命免疫,重现再生。

整体免疫功能检测
· 美国哈佛大学科研成果,
· 获得美国专利印证,
· 一百多项的全身免疫检测,
· 首次从分子层面全面揭秘人体微观与整体器官之间的关系,
· 首次为解决面部衰老问题提供科学依据。
· 获得美国专利印证,
· 一百多项的全身免疫检测,
· 首次从分子层面全面揭秘人体微观与整体器官之间的关系,
· 首次为解决面部衰老问题提供科学依据。
整体免疫体液检测
依托全球尖端的整体检测机构—美国Genova Diagnostics公司,它是全球最大的精准功能检验中心,获得了美国联邦政府临床实验室CLIA的认证,代表了国际最高水平权威临床检验认证。Genova Diagnostics不仅拥有常规领域检测,更有其特有的超过125种专业检测评估,覆盖的生理领域包括免疫、神经、代谢功能等,远远超出普通临床常规检测,从而为整体医学、功能医学等提供人体系统化的生理标本检测数据。

整体免疫细胞生化检测



